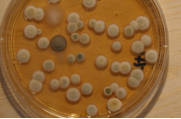

Informationen zu Schimmelpilzen
Schimmelpilzwachstum und erhöhte Schimmelpilzzahlen im Innenraum werden bevorzugt durch
Feuchte und ein schlechtes Raumklima verursacht. Schimmelpilze können Sporen und
Pilzbestandteile sowie Riech- bzw. Schadstoffe an die Umgebungsluft abgeben (sog. MVOC) und
gefährliche Gifte produzieren (sog. Mykotoxine). Sie kommen als natürliche Mikroorganismen in der
Luft, auf Oberflächen und im Hausstaub vor. Schimmelpilze können insbesondere bei kranken und
immungeschwächten Personen Pilzerkrankungen verursachen (sog. Mykosen). Die Sporen und
andere Bestandteile der Schimmelpilze gehören zu den wichtigsten Innenraumallergenen. In
einigen Fällen wurde bei Pilzbelastungen im Innenraum auch ein erhöhtes Infektionsrisiko
gegenüber Bakterien beobachtet.
BAUBIOLOGISCHE MESSTECHNIK
Zur Untersuchung von Pilzen und Bakterien können Luft-, Oberflächen-, Staub-, Material- und
Flüssigkeitsanalysen vorgenommen werden. Es existieren hierbei unterschiedliche
Analyseverfahren, die oft nebeneinander eingesetzt werden wie z.B.:
•
Bestimmung der Konzentration lebensfähiger Keime (KBE) über Nährböden und Bebrütung
•
Bestimmung der Konzentration von Pilzfragmenten und Sporen unter dem Mikroskop
•
Chemische Analysen von MVOC und Mykotoxinen
Die situationsangepasste Kombination verschiedener Diagnosemethoden und das
Zusammenführen diverser Ergebnisse und Eindrücke steigert insbe-sondere bei
Schimmelbelastungen die analytische Sicherheit und macht Quellenzuordnungen und sinnvolle
Bewertungen erst möglich, z.B. die Unter-suchung von Luft, Oberflächen, Staub, Material und
Hohlräumen mit Kultivierung auf Nährböden, mikroskopischer Bestimmung nicht kultivierbarer Pilze
und Pilzfragmente, toxikologische Analysen, Raumklima- und Feuchtemessungen ...
Ein wichtiges baubiologisches Werkzeug zur Ermittlung einer Schimmelpilzursache stellt die
Raumklima-Langzeitaufzeichnung dar. Hier werden mit mehreren Sensoren über mehrere Tage
Klimadaten simultan von der Raum- und Außenluft sowie von auffälligen Wandflächen
aufgezeichnet. Die Ergebnisse liefern Hinweise auf die Beteiligung des Nutzerverhaltens
(Raumlüftung) und der baulichen Gegebenheiten (Wärmebrücke).
•
Angebote zu Schimmelpilzuntersuchungen •
weitere Informationen zu Schimmelpilzen
•
weitere Informationen zu Schimmelpilzen Folgende Vorträge und Veröffentlichungen stehen auch als download zur Verfügung:
•
Haumann Th.; "Schimmelpilze und Raumlüftung / Schimmelprävention –
Lüftungsanlagen ja oder nein?" Fachveranstaltung der Verbraucherzentrale NRW im
November 2011
•
Haumann Th.; "Schimmel – Was nun? - Richtige Vorgehensweise bei
Schimmelpilzbefall im Innenraum" Informationsveranstaltung der Verbraucherzentrale im
Februar 2012
Folgende Vorträge und Veröffentlichungen stehen auch als download zur Verfügung:
•
Haumann Th.; "Schimmelpilze und Raumlüftung / Schimmelprävention –
Lüftungsanlagen ja oder nein?" Fachveranstaltung der Verbraucherzentrale NRW im
November 2011
•
Haumann Th.; "Schimmel – Was nun? - Richtige Vorgehensweise bei
Schimmelpilzbefall im Innenraum" Informationsveranstaltung der Verbraucherzentrale im
Februar 2012
 •
weitere Informationen zu Schimmelpilzen
•
weitere Informationen zu Schimmelpilzen Folgende Vorträge und Veröffentlichungen stehen auch als download zur Verfügung:
•
Haumann Th.; "Schimmelpilze und Raumlüftung / Schimmelprävention –
Lüftungsanlagen ja oder nein?" Fachveranstaltung der Verbraucherzentrale NRW im
November 2011
•
Haumann Th.; "Schimmel – Was nun? - Richtige Vorgehensweise bei
Schimmelpilzbefall im Innenraum" Informationsveranstaltung der Verbraucherzentrale im
Februar 2012
Folgende Vorträge und Veröffentlichungen stehen auch als download zur Verfügung:
•
Haumann Th.; "Schimmelpilze und Raumlüftung / Schimmelprävention –
Lüftungsanlagen ja oder nein?" Fachveranstaltung der Verbraucherzentrale NRW im
November 2011
•
Haumann Th.; "Schimmel – Was nun? - Richtige Vorgehensweise bei
Schimmelpilzbefall im Innenraum" Informationsveranstaltung der Verbraucherzentrale im
Februar 2012
Sachverständigenbüro
für Umweltanalytik
und Baubiologie, Essen
Dr. rer. nat.
Thomas Haumann
Diplom-Chemiker,
Baubiologe IBN, VDB zert.
Radon-Fachperson
Am Ruhrstein 59
D-45133 Essen
Tel: +49 201 615 9862
Fax: +49 201 615 9863
thomas.haumann@gmx.net
www.drhaumann.de
Innenraumschadstoffe
Radon und Radioaktivität
Feuchte und Schimmelpilze
Partikel und Fasern
Raumklima und Gerüche
Elektromagnetische Felder
und Wellen
Untersuchungen
Beratung
Gutachten
Fortbildung
Vorträge
Forschung
Mitgliedschaften:
Fachverband für
Strahlenschutz e.V.
Verband Baubiologie e.V.
Berufsverband Deutscher
Baubiologen, VDB e.V.

















© Dr. Thomas Haumann 01/2021